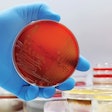

Pet-Cal tablets provide a highly palatable source of calcium, phosphorus and vitamin D to support strong, healthy bones and teeth in both dogs and cats. Pet-Cal tablets provide calcium, phosphorus and vitamin D. Pet-Cal tablets come in 60 and 180-count varieties.
Zoetis Pet-Cal dog and cat treats
Fill out the form below to request more information about Zoetis Pet-Cal dog and cat treats
More From Zoetis